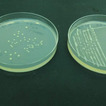

Badania ziemniaków. Rolnicy mogą skorzystać z bonifikaty

fot. GIORiN
Jedną z kluczowych chorób wpływających# na obniżenie plonów ziemniaków jest bakterioza pierścieniowa ziemniaka, wywoływana przez bakterię Clavibacter sepedonicus. Diagnostyka tej bakterii w próbkach bulw ziemniaków pobranych przez inspektorów PIORiN jest skomplikowanym procesem, wymagającym zastosowania zaawansowanych metod laboratoryjnych.
Laboratoria muszą potwierdzić obecność bakterii poprzez szereg testów. Wśród nich znajdują się test immunofluorescencji pośredniej, który pozwala na identyfikację bakterii na podstawie kształtu i siły fluorescencji, oraz testy molekularne PCR/RLFP i real-time PCR, które wykrywają specyficzne fragmenty DNA bakterii. Dodatkowo, stosuje się metody hodowlane na selektywnych podłożach zawierających antybiotyki, które umożliwiają izolację czystych kultur bakterii z ekstraktu ziemniaka. Weryfikacja szkodliwości bakterii odbywa się także poprzez testy biologiczne i patogeniczności, które sprawdzają, czy bakteria jest w stanie wywołać chorobę u roślin wskaźnikowych, co potwierdza jej szkodliwość dla ziemniaków.
W ostatnich latach wprowadzenie badań molekularnych skróciło okres oczekiwania na wynik pozytywny badania próbek, w których stwierdzono Clavibacter sepedonicus. W przypadku niektórych próbek podejrzanych o porażenie bakterią, gdzie niezbędne jest zastosowanie tzw. długiej procedury, konieczne jest wykonanie od 10 do 12 testów, a sam proces badawczy może trwać nawet do 12 tygodni.
Badania laboratoryjne są wykonywane przez laboratoria PIORiN, które stosują międzynarodowo uznane metody badawcze i posiadają akredytację Polskiego Centrum Akredytacji. Sprawozdania z badań wydawane przez takie laboratoria są uznawane w Unii Europejskiej i świadczą o wysokiej jakości i zaufaniu do wyników badań laboratoryjnych.
Dzięki rozporządzeniu Ministra Rolnictwa i Rozwoju Wsi z 6 lutego 2025 r., rolnikom przysługuje 90% obniżka kosztów z tytułu pobrania prób i przeprowadzania badań bulw ziemniaka, przeznaczonych do sadzenia innych niż sadzeniaki, pod kątem porażenia utajonego przez bakterie: Clavibacter sepedonicus (bakterioza pierścieniowa ziemniaka) i Ralstonia solanacearum (śluzak).
O pomoc może ubiegać się podmiot, który:
• posiada status mikro-, małego lub średniego przedsiębiorstwa w rozumieniu przepisów załącznika I do rozporządzenia Komisji (UE) 2022/2472 oraz
• złożył stosowne oświadczenie w ww. zakresie.
Wielkość partii bulw ziemniaka, poddanych próbobraniu i badaniom, łącznie w danym roku nie może być większa niż:
• 25 ton – w przypadku podmiotu profesjonalnego (zarejestrowanego w urzędowym rejestrze podmiotów profesjonalnych),
• 3,75 tony – w przypadku podmiotu nieprofesjonalnego.
Zawarte w rozporządzeniu rozwiązanie traktowane jest jako pomoc publiczna w rolnictwie, które jest zgłaszane przez PIORIN w Systemie Rejestracji Pomocy Publicznej.
Więcej informacji można uzyskać tutaj oraz kontaktując się z właściwym Wojewódzkim Inspektoratem.
Źródło: Główny Inspektorat Ochrony Roślin i Nasiennictwa
Galeria

Czytaj również
Dodaj komentarz
LOKALNY HIT
Jedno z najlepszych miejsc na regenerację. Wykorzystaj ten czas

Drzewa przyprószone śniegiem, cisza i #spokój - słychać jedynie skrzypienie śniegu pod butami - zima w lesie ma swój bajkowy urok.
(czytaj więcej)Trwa karnawał. W jakie dni wypadają święta wielkanocne w tym roku?

Rozpoczął się okres karnawału# - czas radości, zabaw i spotkań w gronie rodziny oraz przyjaciół. To okres, który kojarzy się z balami, imprezami i wesołą atmosferą. Karnawał potrwa aż do Wielkiego Postu.
(czytaj więcej)"Królowa Twojego ogrodu". Pamiętaj o dokarmianiu ptaków

Zimą nie zapominamy dokarmianiu #ptaków. Na osiedlach, w miejskich blokowiskach czy w zaciszu przydomowych ogrodów widać wywieszone słoniny czy napełnione karmniki.
(czytaj więcej)Jaki jest zasięg internetu w Polsce? Przygotowano raport

Ministerstwo Cyfryzacji udostępniło kolejną edycję #raportu „Polska w zasięgu stacjonarnego dostępu do internetu”, prezentującą dane aktualne na koniec czwartego kwartału 2025 r. Publikacja jest kompleksowym źródłem informacji o stanie infrastruktury szerokopasmowej w Polsce. Obejmuje cały kraj, z podziałem na województwa oraz jednostki samorządu terytorialnego.
(czytaj więcej)








Komentarze (0) Zgłoś naruszenie zasad
Uwaga! Internauci piszący komentarze na portalu biorą pełną odpowiedzialność za zamieszczane treści. Redakcja zastrzega sobie jednak prawo do ingerowania lub całkowitego ich usuwania, jeżeli uzna, że nie są zgodne z tematem artykułu, zasadami współżycia społecznego, a także wówczas, gdy będą naruszać normy prawne i obyczajowe. Pamiętaj! -pisząc komentarz, anonimowy jesteś tylko do momentu, gdy nie przekraczasz ustalonych zasad.
Komentarze pisane WIELKIMI LITERAMI będą usuwane!